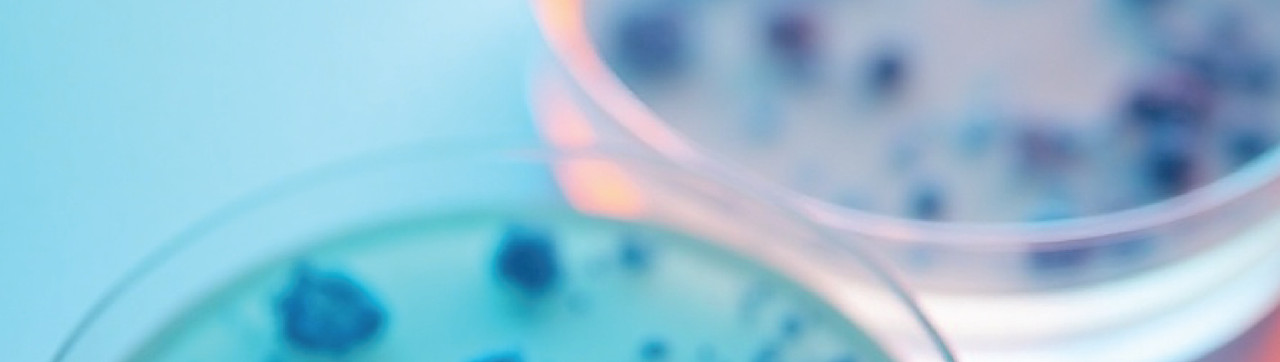
TBX Chromogenic Agar: Research-Based Strengths and Limitations in E. coli Detection

When it comes to detecting Escherichia coli, especially in regulated or high-stakes environments such as clinical microbiology, food safety labs, and pharmaceutical QC, choosing the right chromogenic medium is vital. One frequently used formulation is TBX Chromogenic Agar (Tryptone Bile X-Glucuronide), valued for its selectivity and ease of colony identification.
Recent studies have further validated its performance—while also revealing important nuances that any lab professional should understand.
Comparative Study: TBX Agar Shows High Compatibility with Non-O157 STEC Serogroups
A comparative media study published on PubMed assessed six chromogenic agar media, including TBX, for their effectiveness in isolating non-O157 Shiga toxin-producing E. coli (STEC). These serogroups (such as O26, O103, O111, O121, O145) are increasingly recognized in foodborne outbreaks and public health alerts.
The findings were compelling:
- TBX supported the growth of all non-O157 STEC strains tested, making it one of the more universally supportive media among those compared.
- The medium's use of X-glucuronide as a chromogenic substrate enables straightforward visual identification of coli colonies, which appear as blue-green due to β-D-glucuronidase (GUD) activity.
This reinforces TBX's utility as a first-line medium for STEC screening, especially where broad strain coverage is required.
For labs conducting routine water testing, food microbiology, or environmental surveillance, TBX offers strong confidence in detecting a wide range of E. coli strains with minimal risk of false negatives—at least for GUD-positive strains.
Detection Limitation: E. coli O157:H7 and the β-Glucuronidase Gap
However, the very mechanism that makes TBX so visually effective can lead to missed detections of certain high-risk strains. Notably, E. coli O157:H7—a major foodborne pathogen—typically lacks the enzyme β-D-glucuronidase.
Because TBX chromogenic agar relies on this enzymatic activity to generate a color reaction:
- Colonies of coli O157:H7 often appear colorless or do not display the characteristic blue-green hue.
- This can result in underreporting or false negatives, particularly if labs rely solely on visual screening.
These findings have been highlighted by both Fujifilm Wako Chemicals and Innovation Diagnostics Inc., emphasizing the importance of secondary confirmatory testing, such as immunological or molecular assays (e.g., PCR for stx1, stx2, or eae genes), when O157:H7 detection is critical.
This limitation is especially relevant for:
- Clinical microbiology labs identifying O157-linked infections
- Food safety authorities screening beef or fresh produce
- QC labs in industries where pathogen exclusion is regulatory
Practical Lab Takeaways
For molecular biologists, diagnostic specialists, and procurement officers managing microbiological workflows, these insights help clarify how and when to deploy TBX agar most effectively:
- Use TBX for routine coli screening, including environmental, food, and water samples.
- Complement TBX with alternative media or PCR-based methods when O157:H7 is a target organism.
- Ensure that any TBX formulation used meets relevant ISO specifications (e.g., ISO 16649-2) to ensure quality and compliance.
Conclusion: A High-Value Tool with Known Boundaries
TBX Chromogenic Agar remains a widely validated and essential medium in microbiological detection. Studies confirm its broad detection range for GUD-positive E. coli, making it ideal for general screening. At the same time, understanding its selective mechanism ensures labs can adapt protocols appropriately—particularly when pathogenic strains like O157:H7 are of concern.
With growing attention to non-O157 STEC outbreaks, the use of TBX—paired with confirmatory molecular diagnostics—offers a powerful, research-backed strategy for comprehensive E. coli monitoring in diverse lab environments.